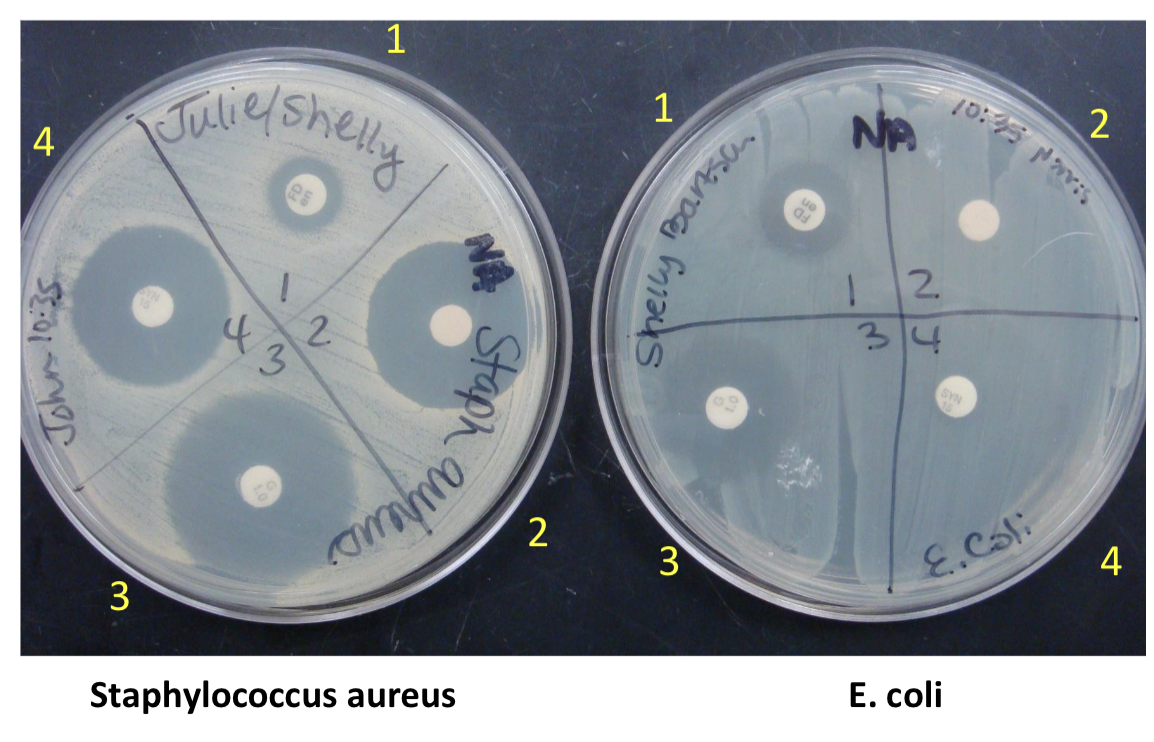
<p>greater diameter</p>
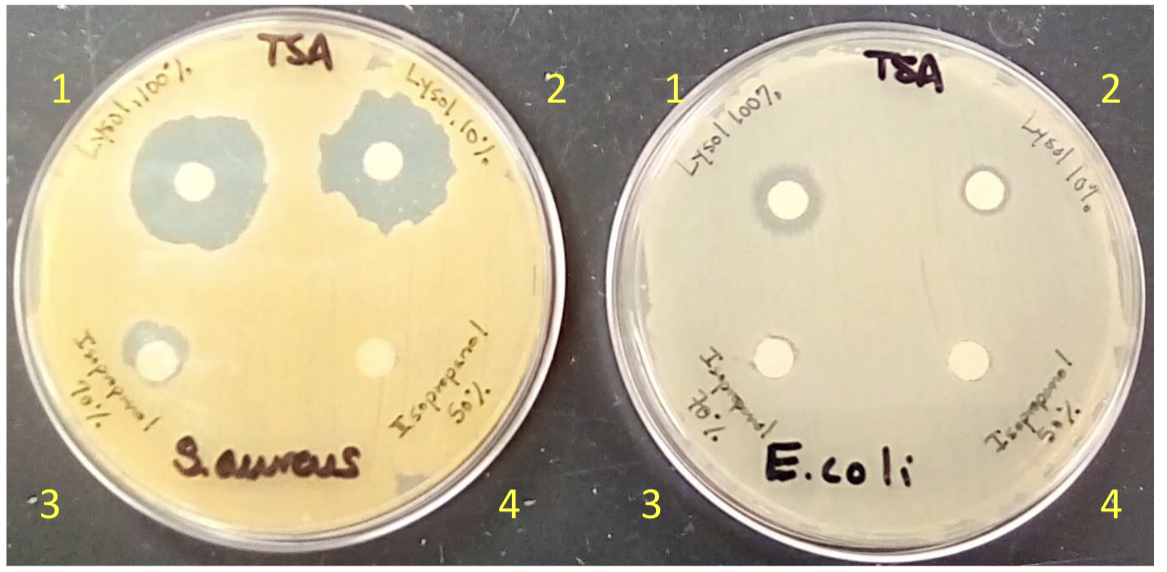
<p>what is this?</p>
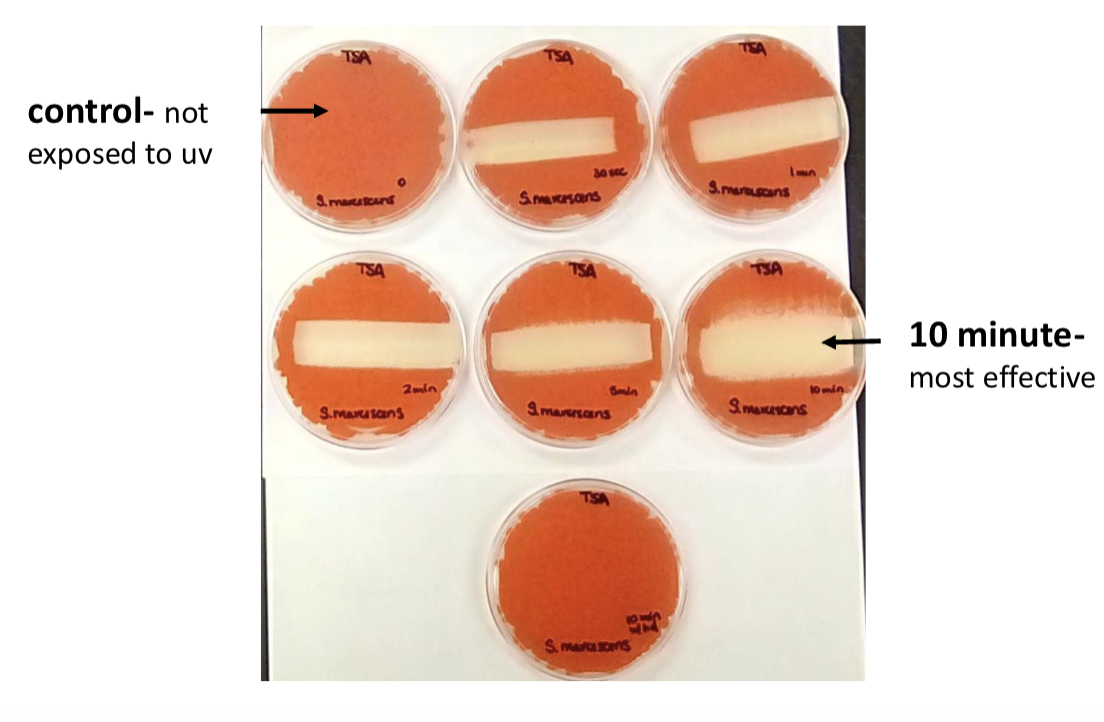
<p>what form of mutation is caused by exposure to uv light</p>
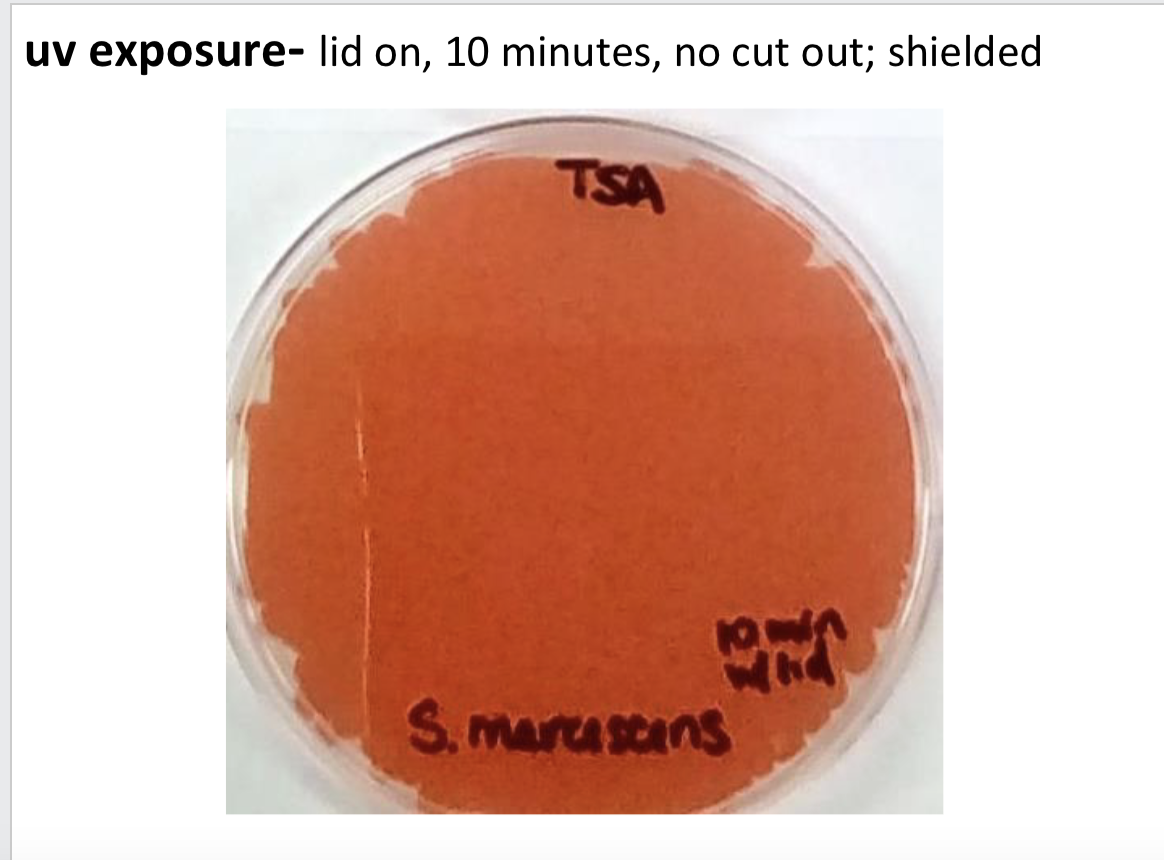
<p><span>3 factors determine effectiveness of uv treatments</span></p>
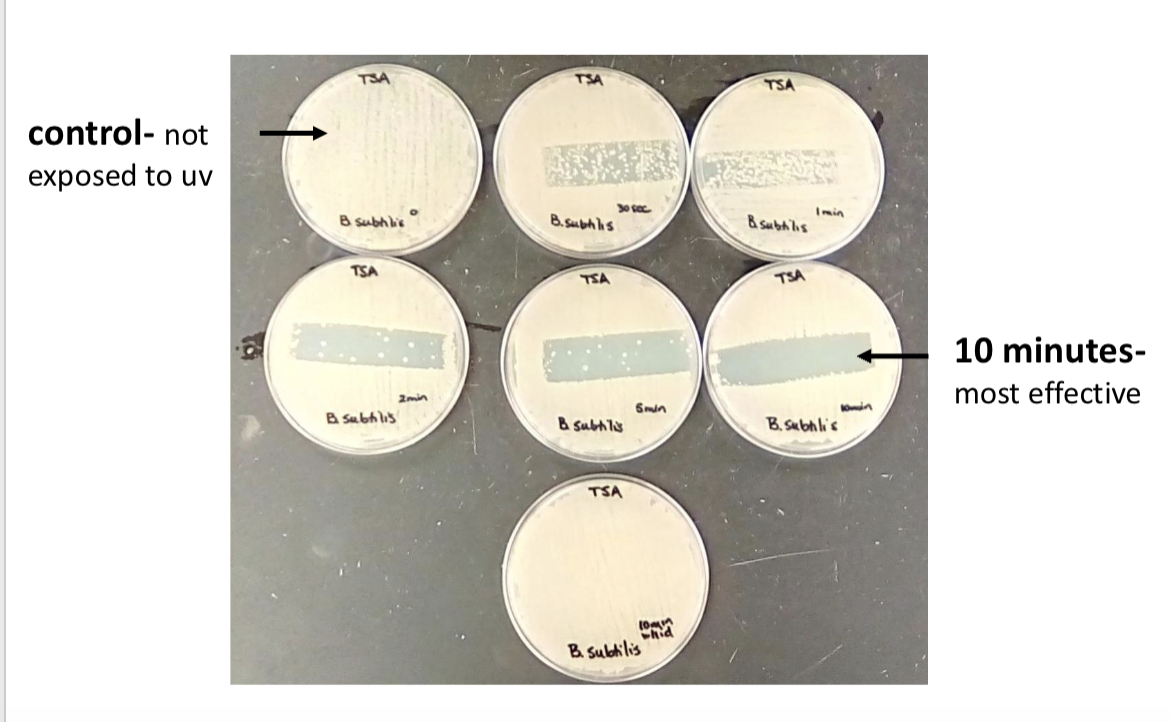
<p>what does bacillus make?</p>
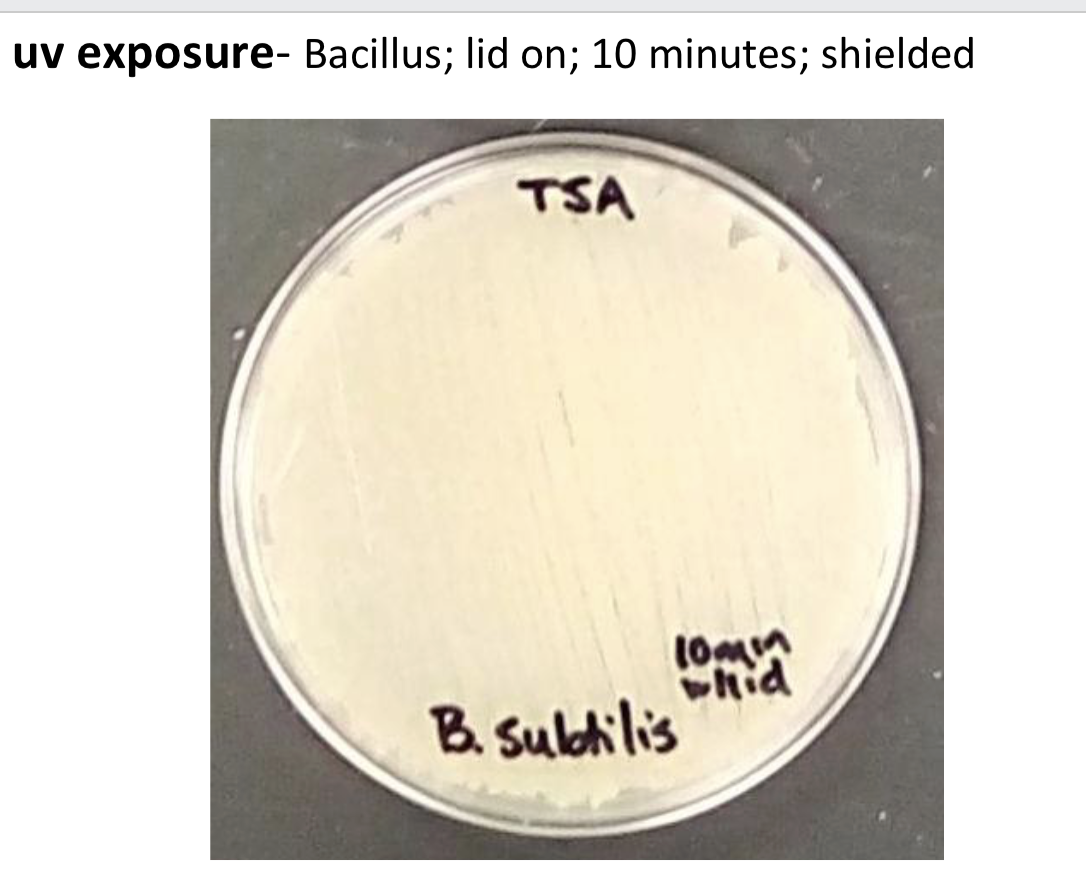
<p>why does the plate that was irradiated 2 minutes with the lid on grow <strong><u>normally</u></strong>?</p>

1/26
Looks like no tags are added yet.
Name | Mastery | Learn | Test | Matching | Spaced | Call with Kai |
|---|
No analytics yet
Send a link to your students to track their progress

what’s this?
kirby-bauer antibiotic test

what are we comparing?
the sensitivity and resistance of gram positive and gram negative

no growth around disc mean?
sensitive

to determine the effectivness of antibiotic on growth we?
measure the inhibition in mm

if there’s regrowth in zone of inhibition it means?
bacteria had preexisting mutation for resistance
greater diameter
greater effectiveness

no clearing
bacteria resistant
what is this?
disinfectant and antiseptic test

what are we comparing?
sensitivity and resistance of gram positive and gram negative bacteria

no growth around disc means
sensitive

growth around disc is?
resistant

what do we measure?-clearing
zone of inhibition around disc

what’s this?
uv light box

what bacteria is this?
serratia marcescens

what is this called?
uv radiation

how many nm?what wavelenght of uv light was used in our expirement?
254 nm
what form of mutation is caused by exposure to uv light
thymine dimers

if theres no growth it means?
sensitive to uv

uv must directly … the bacteria to kill bacteria
contact
3 factors determine effectiveness of uv treatments
time of exposure, amount of shielding, distance from bacteria

what bacteria is this?
bacillus
what does bacillus make?
endospores

when does uv exposure effectively kill bacteria ?
uv must directly contact bacteria to kill bacteria

name the 2 variables that we tested that influence the effectivness of uv exposure
uv exposure and amount of shielding

why is bacillus more resistance to uv exposure than serratia?
make endospores
why does the plate that was irradiated 2 minutes with the lid on grow normally?
lid blocked the UV light .

uv light can have?
mutation repair-dna repair